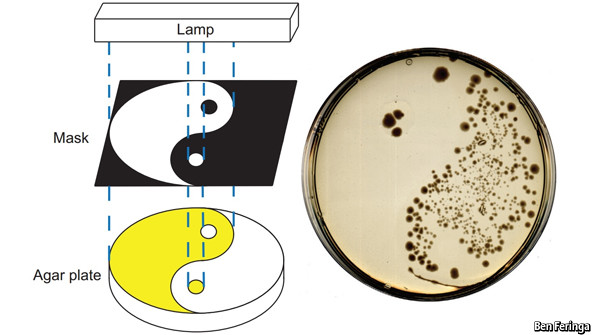

Solar cells were once a bespoke product, reserved for satellites and military use. In 1977 a watt of solar generating capacity cost $77. That has now come down to about 80 cents, and solar power is beginning to compete with the more expensive sort of conventionally generated electricity. If the price came down further, though, solar might really hit the big time—and that is the hope of Henry Snaith, of Oxford University, and his colleagues. As he described recently in Science, Dr Snaith plans to replace silicon, the material used to make most solar cells, with a substance called a perovskite. This, he believes, could cut the cost of a watt of solar generating capacity by three-quarters.
When light falls on a solar cell, it knocks electrons away from the cell’s material and leaves behind empty spaces called holes. Electrons and holes then flow in opposite directions and the result is an electric current. The more electrons and holes there are, and the faster they flow, the bigger the current will be.
Perovskites are substances composed of what are known as cubo-octahedral crystals—in other words, cubes with the corners cut off. They thus have six octagonal faces and eight triangular ones. Perovskite itself is a naturally occurring mineral, calcium titanium oxide, but lots of other elemental combinations adopt the same shape, and tinkering with the mix changes the frequency of the light the crystal absorbs best.
Dr Snaith’s perovskite is a particularly sophisticated one. It has an organic part, made of carbon, hydrogen and nitrogen, and an inorganic part, made of lead, iodine and chlorine. The organic part acts as a dye, absorbing lots of sunlight. The inorganic part helps conduct the electrons thus released.
It is also cheap to make. Purifying silicon requires high (and therefore costly) temperatures. Dr Snaith’s perovskite can be blended at room temperature. Laboratory versions of cells made from it cost about 40 cents per watt (ie, about half the cost of commercial silicon-based solar cells). At an industrial scale, Dr Snaith expects, that will halve again.
There are caveats, of course. The new perovskite is such a recent invention that its durability has not been properly tested. Many otherwise-promising materials fail to survive constant exposure to the sun, a sine qua non of being a solar cell. And the process of converting a laboratory-made cell into a mass-manufactured one is not always straight forward.
If it leaps these hurdles, though, Dr Snaith’s material will be a strong challenger for silicon. As solar power-generation becomes a mainstream technology over the next few years, the once-strange word “perovskite” may enter everyday language.
First published on economist.com.